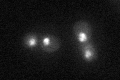
YDR310C
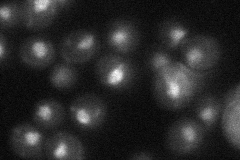
YDR310C
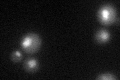
YDR310C

View description
Transcriptional repressor required for mitotic repression of middle sporulation-specific genes; also acts as general replication initiation factor; involved in telomere maintenance, chromatin silencing; regulated by pachytene checkpoint
Localization:
Intensity:
Fold change:
Significance:
-
C’ GFP library in SD
nucleus30.35 -
N' NOP1pr-GFP in SD

nucleus74.0248 -
N' TEF2pr-mCherry in SD

vacuole77.0046 -
N' NATIVEpr-GFP in SD
nucleus29.8171 -
N' TEF2pr-VC and Cyto-VN in SD

#N/A0 -
C’ GFP library in SD+DTT
nucleus22.370.73No -
C’ GFP library in SD+H2O2

nucleus33.321.09No -
C’ GFP library in Starvation Media

nucleus25.950.85No -
C’ GFP library on the background of Pup2-DaMP

nucleus -
C’ GFP library on the background of CCT mutant

nucleus28.98970.955003No
